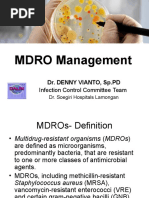

0% found this document useful (0 votes)
49 views2 pagesUnderstanding Bartonellosis Disease
Bartonellosis, also known as Carrion's disease, is caused by the bacterium Bartonella bacilliformis. It is transmitted by sandfly bites and found exclusively in Peru, Ecuador, and Colombia. The disease has two stages - an acute phase with symptoms like anemia and jaundice, and a chronic phase with splenomegaly, joint pain, and muscle pain. Without treatment, the mortality rate can be as high as 85%. Diagnosis involves blood tests and smears to detect the bacteria, and treatment consists of antibiotics like chloramphenicol or ciprofloxacin.
Uploaded by
Michelle San Miguel FeguroCopyright
© © All Rights Reserved
We take content rights seriously. If you suspect this is your content, claim it here.
Available Formats
Download as DOCX, PDF, TXT or read online on Scribd
0% found this document useful (0 votes)
49 views2 pagesUnderstanding Bartonellosis Disease
Bartonellosis, also known as Carrion's disease, is caused by the bacterium Bartonella bacilliformis. It is transmitted by sandfly bites and found exclusively in Peru, Ecuador, and Colombia. The disease has two stages - an acute phase with symptoms like anemia and jaundice, and a chronic phase with splenomegaly, joint pain, and muscle pain. Without treatment, the mortality rate can be as high as 85%. Diagnosis involves blood tests and smears to detect the bacteria, and treatment consists of antibiotics like chloramphenicol or ciprofloxacin.
Uploaded by
Michelle San Miguel FeguroCopyright
© © All Rights Reserved
We take content rights seriously. If you suspect this is your content, claim it here.
Available Formats
Download as DOCX, PDF, TXT or read online on Scribd